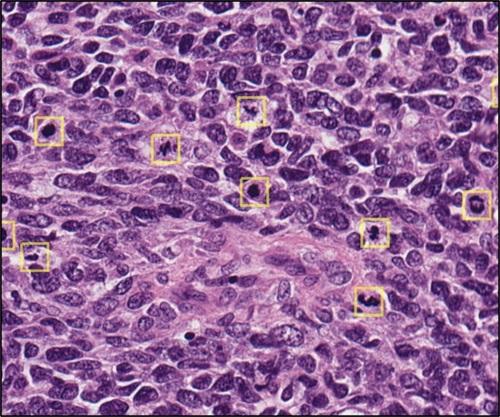
MitPro-Next-Generation-Mitosis-Profiling-

Aperio AI Store Gallery
CRC Macrodissect AI
Tissue Type:
Colorectal
Biomarker / Stain:
H&E
AI Functions:
Macrodissection, Tumor Finder, Workflow Orchestration
Company Name:
Indica Labs
Regulatory Status:
RUO
Lung Macrodissect AI
Tissue Type:
Lung
Biomarker / Stain:
H&E
AI Functions:
Macrodissection, Tumor Finder, Workflow Orchestration
Company Name:
Indica Labs
Regulatory Status:
RUO
Lung PD-L1 AI
Tissue Type:
Lung
Biomarker / Stain:
PD-L1
AI Functions:
Biomarker Quantification, Tumor Finder
Company Name:
Indica Labs
Regulatory Status:
RUO
Lunit SCOPE PD-L1 22C3 TPS
Tissue Type:
Lung
Biomarker / Stain:
PD-L1
AI Functions:
Biomarker Quantification, Tumor Scoring/Grading
Company Name:
Lunit
Regulatory Status:
RUO
MitPro: Next-Generation Mitosis Profiling
Tissue Type:
Multi-Tissue
Biomarker / Stain:
H&E
AI Functions:
Mitotic Counting
Company Name:
Histofy
Regulatory Status:
RUO
SlideQC BF
Tissue Type:
Multi-Tissue
Biomarker / Stain:
H&E, IHC
AI Functions:
Quality Control, Workflow Orchestration
Company Name:
Indica Labs
Regulatory Status:
NMD
Prostate AI
Tissue Type:
Prostate
Biomarker / Stain:
H&E
AI Functions:
Tumor Finder, Tumor Scoring/Grading
Company Name:
Indica Labs
Regulatory Status:
RUO